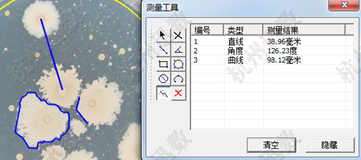

咨詢熱線:
18753190152

產品介紹
icount系列是迅數科技2013最新推出的第四代智能菌落計數儀。全新設計的三色LED混合光源,消除了上一代白光LED照明偏藍問題,能真實還原菌落色澤。上光源呈360度環繞分布,視場更均勻;新設計的晶銳懸浮式暗視野,極大地提高了暗視野的襯度,更適合微小菌落的觀察。 icount20是icount系列中面向基層微生物實驗室的增強型菌落計數儀,不僅具備一鍵智能模式,增設了動態調節、偏差預估、雜質剔除統計,適應面更為廣泛。
全封閉照明
采用全封閉、寬光帶照明技術,符合人體工學的舷窗門設計,隔絕環境光的干擾,徹底消除雜散光在玻璃培養皿折射形成的光斑、光環現象,為精確菌落計數提供了常備的光影條件。

三色LED光源
長壽命、低功耗、環保型三色LED混合光,還原真實的菌落色澤,消除白光LED照明成像偏藍的問題。

一鍵智能模式
提供6種一鍵統計模塊,可一鍵完成不同培養皿中菌落的精確分割和計數,使菌落統計簡單化、便捷化。

***級統計
提供2種***級統計算法,可通過設置相關參數,實現菌落精確計數,適合復雜平皿的統計情況。

雜質剔除
微生物菌落計數過程中常存在雜質問題,如未經過濾的樣本直接注入培養皿,培養基中存在不溶物、氣泡、瓊脂凝塊等。可利用雜質與目標菌落在形狀、顏色等方面的差異,實現菌落的準確統計。

排除污染區域
對菌落統計結果中的誤統計情況,可利用區域消除工具繪制任意形狀包圍誤統計區域,即可消除對選定區域的菌落統計結果。

手動測量
對手動繪制的任意直線、角度、曲線進行自動測量,并生成測量結果。
數據管理
系統采用開放式的實驗報告打印方式,即可將統計信息導出至EXCEL中,并根據行業需求,編輯報告格式。
為保護實驗數據的真實性和原始性,系統設置三種密碼:程序啟動密碼、數據庫密碼和管理員密碼。

產品價:詳情頁中并未標注產品具體價格,如需購買,請拍下之后聯系客服改價格。
付款問題:本商城支持支付寶支付、微信支付、線下銀行打款等幾種形式,付款之前請咨詢客服具體事宜。
主要功能與技術指標
一、照明系統
|
可見光 |
高亮三色LED結構光 |
|
全封閉暗箱 |
消除環境雜散光干擾 |
|
上光源 |
場景式360°柔性無影光照明 |
|
下光源 |
晶銳懸浮式暗視野照明 |
上光、下光、雙光,自由切換,光強可調
二、數字成像
·標清工業定焦鏡頭
·500萬像素專業型CMOS相機
三、菌落分析模塊
1.基本菌落計數功能
|
平皿類型 |
傾注、涂布、膜濾 |
|
全皿菌落統計 |
菌落總數統計,并按25檔尺寸分類顯示 |
|
區域選擇統計 |
可選擇圓形、矩形、任意圈定區域進行統計 |
|
直徑分類統計 |
設置直徑范圍,統計特定大小的菌落 |
|
鼠標點擊統計 |
快速標記、添加菌落,適合培養皿邊緣菌落的計數 |
|
菌落粘連分割 |
自動分割相互粘連的菌落,鏈狀菌落由用戶選擇分割或不分割 |
一鍵智能計數(6模式)
2.高級菌落統計功能
·動態調節統計
·偏差預估統計
·雜菌、雜質剔除
3.高級工具
|
網格清除 |
消除濾膜網格背景干擾 |
|
人工計數修正 |
添加或刪除菌落 |
|
排除污染區域 |
鼠標勾勒任意污染區域,自動剔除污染區域的菌落數 |
|
人工粘連分割 |
手動分割多重粘連菌落 |
|
參數自動換算 |
培養皿直徑、樣本稀釋度輸入,實現自動換算 |
4.標定與測量
|
儀器標定 |
儀器自帶標定、人工修正標定 |
|
全皿自動測量 |
全皿菌落的等效直徑、面積、長短徑、周長、圓度分析 |
|
手動精確測量 |
長度、角度、弧度、面積、弧線、任意曲線 |
四、數據庫模塊
·數據存儲、智能查詢
·數據導出:統計結果以Excel表導出
·數據安全:操作者使用權限,數據修改權限設置
五、儀器規格與配置
·icount 20 主機1臺
·菌落分析軟件
·品牌商務液晶電腦
版權所有:山東博科科學儀器有限公司|生物安全柜生產廠家,醫用品牌,價格,報價
![]()
備案號:魯ICP備17040084號-15 魯公網安備37010102000422號
魯械廣審(文)第2021052198號






